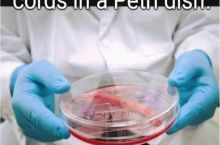

Trending Videos
Next Posts

Feel better yet?

Really got it nice and clear

Fast Food Banter

Burned to ashes

Can never be too sure

One case that Animal protection cannot solve

How T-shirts are made

The ideal Uber ride

Shut up nerd.

YouTube

Thought of sharing -

A *DOG*

What smells

Software engineers like

Yes or No

Always check the temperature first

My parents should appreciate me

Hello girls

You stay

Well, it's interesting

Please don't

British Florida then?

Just getting on with my day as usual.

Maybe not always

I trust you

Good for you brian

Illusions!!!

Watch were you step

Great guy

"I'm as surprised as you are!"

I diagnose that with epic

LOOUUIIISSAAA JEENNNKKIINNSSS

I can do this! I CAN!

No r*pe jokes

Suprise!!!

Delet dis

When I try to hit on a girl

I'm smart every one and a while.....

My moms text to my sister

I mean..

He gots the flu

Hehe into the wind

Gamer moment

Nice beard man !

Because i don't want to be banned

Finally someone has come to his senses

What's legal is illegal now

Well my day just got better

Classic Anna Kendrick

I once slept for 48 hrs

Only the most inquisitive would want to know!

I'll be ok

Rather have the duck in my pocket

Just what we need

Go away Keith

And no rollover plans

Yeah Mom

Today’s the day

A boy can dream

Opening scene to a future horror movie....

24 years later, Seinfeld is still relatable.

When mom tells me I'm a handsome man

Overheard at a soccer game

This belongs here too

he was never a dwarf he is a gnome

Good old mike

We’ve found god

Here's some more CK2 shitposting

Swords solve everything

We will just leave this here.

Life isn’t fair

Good Ole Seattle

*smiles* why am i here

It's gonna be hard for them to bond

Kids these days

Google plus can really do whatever it wants

Title of my post

I am still laughing at this.

legitamon't

it's a harsh world

That is pasta concerning

constitution

he must have a big PP

Golden tooth

it be like that

I can't wait for fire pods next year

Sike, you thought you were safe

+18

Mom made me gay

This is so sad
Human vocal cords recreated in lab using stem cells

Mmmmmmmmm Cheap ham

Yesss I need these

Fossilized sloth

No love for UPS?

Someone said Celine Dion looks like Toguro.

nice smell

Chemistry class

Moved into a new apartment and forgot to bring a wine bottle opener. So I thought 'screw it'.

Oh yeah, beg for donations bb

